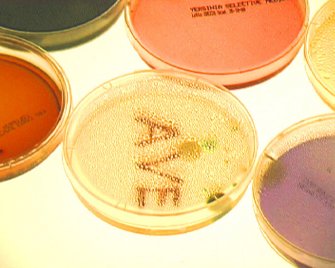
Net0 Annunciazione 3

Annunciazione
Romeo Castellucci
Il volto di Cristo, ritratto in tutta la sua greve umanità dal Masaccio (da un affresco di Santa Maria Novella di Firenze), diviene per lunghi periodi invisibile ruotando vorticosamente fino a confondere i suoi colori. Il Dio che non può e non deve essere visto né nominato, ma solo ricercato e percepito, è un’idea alla base dell’ebraismo e si collega in quest’opera al suo esatto opposto: il mondo invisibile per eccellenza, quello del microcosmo batterico, che si rivela al macrocosmo formando la parola AVE. Un saluto, ma, in tale contesto, anche un simbolo religioso legato al culto mariano, alla donna e alla fecondazione.
Castellucci evidenzia questo aspetto seminando sul terreno di coltura i batteri dell’apparato genitale femminile (Trichomonas vaginalis, Neisseria gonorrhoeae, Candida albicans, Haemophilus ducreyi).